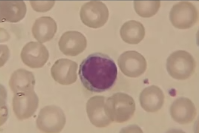

Células NK e dendríticas são originadas de qual célula?
Célula progenitora linfóide.
Como são os grânulos específicos dos eosinófilos?
Possuem uma estrutura central semelhante a um cristal, o internum, rodeado por um externum.

Verdadeiro ou falso.
As hemácias apresentam de 7-8 micrômetros de diâmetro, forma discóide e contêm grande quantidade de hemoglobina.
Verdadeiro.

Verdadeiro ou falso.
Glóbulos vermelhos, eritrócitos e hemácias se tratam do mesmo tipo celular.
Verdadeiro.

Como se formam os macrófagos?
Quais substâncias são predominantes no internum e externum dos eosinófilos?
Podem ser ativados por várias substâncias (Componentes de bactérias, citocinas, etc.). Essa é uma característica de qual célula?
Macrófagos.
Corpúsculos anucleados com forma de disco com cerca de 2-3 micrômetros de diâmetro. Essa descrição se refere à:
Plaqueta.

Verdadeiro ou Falso.
Os leucócitos são uma das primeiras barreiras contra a infecção, participando das defesas celulares e imunocelulares do organismo.
Verdadeiro.
Quais são os leucócitos agranulócitos?
Monócitos e linfócitos.

Constitui 0,5% dos glóbulos brancos, libera heparina e outros mediadores químicos da inflamação, possui núcleo volumoso e irregular com formato de “S”. Essa descrição se encaixa com qual tipo de leucócito?
Basófilos.

A célula progenitora linfóide dá origem a quais tipos celulares?

A célula-tronco multipotente dá origem a 2 famílias de células do sistema sanguíneo, quais são essas famílias?

Quais são os tipos de grânulos presentes no citoplasma das plaquetas?
O que caracteriza os grânulos azurófilos dos eosinófilos?
São características de qual célula?
Linfócito.
Qual é a principal função dos neutrófilos?
Neutrófilo, monócito e megacariócito são originados de qual célula?
Célula progenitora mielóide.
Qual é a primeira célula que sai dos vasos no processo de diapedese para combater o agressor?
Os neutrófilos.
Os glóbulos brancos também são conhecidos como:
Leucócitos.
Verdadeiro ou falso.
Exsudato inflamatório é uma coleção de células leucocitárias de defesa no tecido conjuntivo contra um invasor agressor.
Verdadeiro.
Qual grânulo apresenta as seguintes características:
Grânulos gama ou corpos densos.
Como ocorre a modulação do processo inflamatório realizado pelos eosinófilos?
Quais são os grânulos terciários?